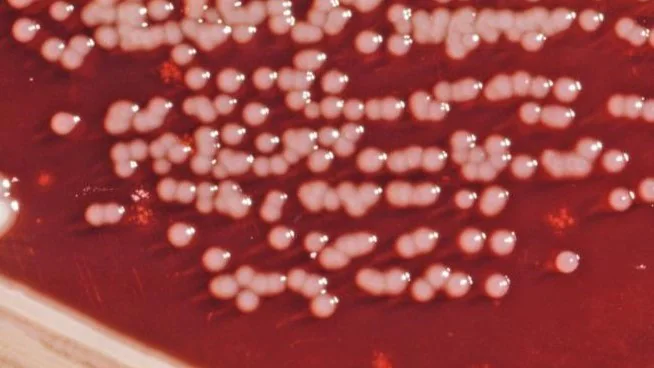
Colonial growth pattern displayed by Gram-negative Yersinia enterocolitica bacteria.

Key points
- People at risk for infection include young children and people with high iron levels.
- Most Yersinia infections can be managed symptomatically.
- Patients with profuse diarrhea should be rehydrated.
- Yersinia are typically resistant to first-generation cephalosporins and most penicillins.
Etiology
Yersinia species are facultative anaerobic gram-negative coccobacilli. The most common species that cause yersiniosis are Yersinia enterocolitica (serogroups O:3, O:5,27, O:8, and O:9), but disease is also caused by Y. pseudotuberculosis.
The term "yersinosis" does not include illness caused by Y. pestis, the causative agent of plague.
Who is at risk
People with diseases that cause high iron levels (e.g., hemochromatosis, thalassemia), including those on iron chelation treatment, are at greater risk for infection and severe disease.
Infection with Y. enterocolitica occurs most often in young children.
Patient counseling
Clinical features
The incubation period is typically 4 to 6 days (range: 1 to 14 days). Symptom onset might be more gradual compared with infections caused by other enteric pathogens.
Enterocolitis is the most common clinical presentation.
Symptoms typically include:
- Abdominal pain
- Diarrhea (can be bloody and can persist for several weeks)
- Fever
Sore throat also can occur, particularly in children.
Mesenteric adenitis, which presents as pain mimicking appendicitis, has been well described.
Diagnosis
Diagnosis is made usually by isolating the organism from bile, blood, cerebrospinal fluid, mesenteric lymph nodes, peritoneal fluid, stool, a throat swab, or wounds.
If yersiniosis is suspected, notify the clinical laboratory because cold enrichment, alkali treatment, or plating of a clinical specimen on CIN agar can be used to increase the likelihood of a positive culture.
Patient management
Most E. coli infections can be managed symptomatically. Patients with profuse diarrhea should be rehydrated.
Y. enterocolitica isolates are usually:
- susceptible to aminoglycosides, third-generation cephalosporins, fluoroquinolones, tetracyclines, and trimethoprim-sulfamethoxazole
- resistant to first-generation cephalosporins and most penicillins
Antimicrobial therapy has no effect on postinfectious sequelae.
Antimotility agents should be avoided for patients with bloody diarrhea; treatment should be reassessed if symptoms have not improved in 48 hours.
No known data show that kaolin-pectin compounds (e.g., Kaopectate®) or lactobacillus slow diarrhea or relieve abdominal cramping.
*The use of trademarks is for identification only and does not imply an endorsement by the Public Health Service or the U.S. Department of Health and Human Services.
Complications
Necrotizing enterocolitis has been described in infants.
Reactive arthritis affecting the wrists, knees, and ankles can occur, usually 1 month after the initial diarrhea episode, resolving after 1–6 months.
Erythema nodosum also can occur, manifesting as painful, raised red or purple lesions along the trunk and legs, usually resolving spontaneously within 1 month.
- Infectious Diseases Society of America: Clinical Practice Guidelines for the Diagnosis and Management of Infectious Diarrhea (2017)
- American Public Health Association: Control of Communicable Diseases Manual